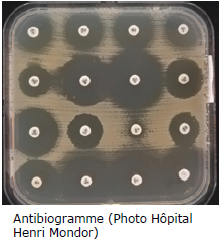

Antimicrobial resistance is a major global health threat.
The World Health Organization (WHO) has declared that antimicrobial resistance is one of the top global public health threats of the 21st century. It is possible that antimicrobial resistance will become the leading cause of death globally, ahead of cancer, accounting for 10 million deaths a year, 90% of which will be in Asia and Africa, due to the scarcity of resources. A more reasoned use of antibiotics is therefore crucial. To this end, a reliable test for bacterial susceptibility to antibiotics is needed. MSF has long been involved in efforts to tackle antimicrobial resistance, primarily in conflict-torn regions where MSF treats people with war wounds that become infected with multidrug-resistant bacteria.
| Antibiogram (Photo: Hôpital Henri Mondor) |
|

In the industrialized world, identifying antimicrobial resistance is relatively simple thanks to automated electronic data systems developed to read and interpret antibiograms.
Microbiologists use Petri dishes containing an agar medium to culture bacteria samples taken from the patient being treated. Paper disks containing a given concentration of each antibiotic are placed in the dishes. The antibiotics diffuse into the agar, killing, or not killing, the bacteria present. If a bacterium is susceptible to the antibiotic, it disappears within a concentric zone around the disk: this is known as the inhibition zone. Antimicrobial resistance is categorized by measuring the diameter of these inhibition zones and comparing these measurements against reference charts, or breakpoint tables (see photograph on the right). Interpretation is based on precise rules specified by microbiologists.
Antibiograms are processed by technicians and are then usually analyzed using antibiogram reader-incubator systems, which are very expensive. Medical microbiology laboratories are thus able to provide clinicians with results that enable them to choose the most suitable drug to treat the patient and prevent the development of drug-resistant bacteria.
In developing countries, identifying antimicrobial resistance is much more complicated, as MSF discovered when it was setting up bacteriology laboratories in five low-resource nations.
To address this problem, Nada Malou, MSF Microbiology advisor, based on her many years of experience in the field, and Amin Madoui, a researcher at the CEA-Genoscope Genomics-Metabolics Laboratory, conceived the project to develop a smartphone application:
We needed an app that
would cost nothing and be user-friendly, and we needed new algorithms to
efficiently process antibiogram images on a smartphone".
MSF Fondation saw the project as an opportunity to develop an innovative technological solution to a very real problem and, in 2018, launched this collaborative project involving a team of scientists based at the Genoscope Genomics-Metabolics Laboratory (CEA/CNRS/Université d’Évry), Evry University Laboratory of Mathematics and Modeling (LaMME - CNRS/Université d’Évry, Genopole site), the Bacteriology department at Henri Mondor hospital (AP-HP Paris hospital system) and MSF, aiming to develop an open-source tool designed to analyze and interpret antibiograms, for use by healthcare professionals worldwide.
Analyzing an antibiogram (or AST e-plate) using the application (from the paper: AI-based mobile application to fight antibiotic resistance).
In 2019, the team was awarded funding under the "Google AI Impact Challenge" for projects aimed at applying Artificial Intelligence (AI) to address issues with strong social impact. This grant has been used to finance human resources (thirteen employees from Google/Google.org Fellows) and to conduct deep learning tests to improve the application's performance in recognizing data entries (the algorithm recognizes the names of every antibiotic).

The application developed works offline, an essential feature for use in countries with limited resources. A photograph of the antibiogram is taken using the phone camera, and the app then guides the user through the analysis steps. The user can interact with the app interface at any point to check and, if necessary, adjust the automatic measurements.
To do this, it combines original algorithms, using machine learning and image processing. Last, an embedded expert system checks that the data is coherent and displays the interpreted results. The measurement procedure is fully automatic and achieves very high levels of reliability, with 98% agreement with the most reliable manual measurement methods currently in use.
The aim now is to adapt the mobile application for use in the low-resource settings in which MSF works. It should then be used to obtain high-quality antibiotic susceptibility tests for patients anywhere in the world, and could help further global surveillance of antimicrobial resistance.
In 2021, MSF is currently assessing the clinical effectiveness of the application in three different countries with a view to deploying its use at MSF laboratories by the end of the year. The app will then be made available to all test laboratories in countries with low resources by 2022.
With just a few months to go before completing these assessments and rolling out the app, MSF is calling on everyone involved in efforts to tackle antimicrobial resistance to come on board to make the app available to as many laboratories as possible in countries with limited resources.